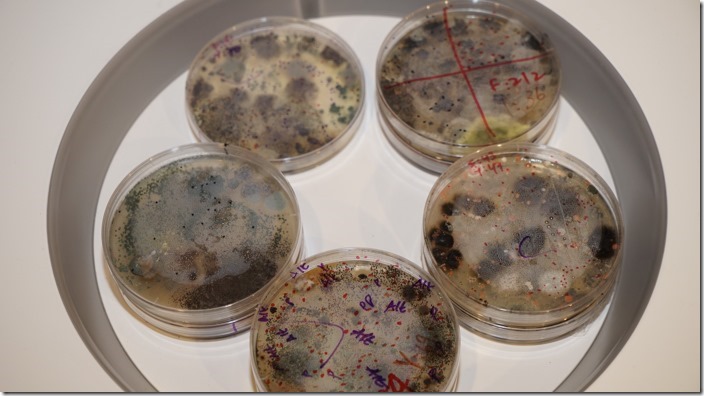
Dyson_V6_020

吸塵器幾乎是家庭必備的打掃清潔用具,但使用者往往會忽略吸塵所排出的氣體,反而造成二次的空氣汙染,這原因就是傳統的吸塵器對於所排出的氣體,並沒有做好過濾就排出。Dyson 這次所推出的新一代 V6 無線手持吸塵器,使用 HEPA 濾網,能捕捉空氣中 99.99% 的 0.3 微米懸浮微粒,除了清除家庭中的髒污與灰塵外,還能讓排出的空氣更清潔。
Dyson 這次推出 Dyson V6 Motorhead 及Dyson V6 Fluffy 兩款無線手持吸塵器,採用多圓錐氣旋科技,先以強大離心力將小到 0.3 微米的塵蟎、霉菌等過敏原與灰塵,先行分離到集塵桶中,排出的氣體,再經過 HEPA 過濾,更能有效捕捉過敏原。
而這次所使用的數位馬達,是 Dyson 第六代數位馬達,其轉數每分鐘高達 11 萬轉,其體積更小,吸力更強大。
Dyson V6 Fluffy 使用軟質碳纖維滾筒吸頭,微塵碎屑一次吸除。柔軟的尼龍負責把大型顆粒捲入吸頭內;碳纖維刷毛則用來清除地板的靜電,以吸走更多微塵。
Dyson V6 Motorhead 採用抗靜電碳纖維電動馬達毛刷吸頭,結合硬質尼龍毛刷及軟質碳纖維絲,硬質尼龍毛刷針對地毯灰塵、軟質碳纖維絲則能吸除地板的碎屑灰塵。
另外針對更輕量的需求,還推出 Dyson V6 Mattress,迷你渦輪吸頭能吸除床墊深層的塵螨、塵螨糞便及老舊皮屑細胞。
Dyson 首次於台灣進行「Dyson居家灰塵研究計畫」,以了解本地的室內污染,還有肉眼看不到的細菌和過敏原。戴森清潔團隊以戴森V6系列無線吸塵器從床墊、地板和傢俱表面收集灰塵樣本,並與台北一所醫學大學合作進行此次的灰塵研究。研究結果發現,近四成家戶的塵蹣過敏原濃度高於標準值10μg/g(微克/克),易引發氣喘病發風險。
此次推出三款與先前 Dyson 所推出的無線手持吸塵器,差異最大的地方在於後方的 HEPA 濾網,可更有效的去除居家的過敏原,讓家中的環境更能保護家中所有成員。
Dyson V6 Mattress 建議售價 NT$15900,Dyson V6 Motherhead 建議售價 NT$23900,以上兩款預計 5 月上市。而 Dyson V6 Fluffy 價格未定,預計 6 月上市。